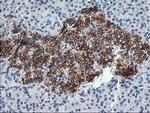
SNAP25 Antibody in Immunohistochemistry (Paraffin) (IHC (P))

Search
OriGene
SNAP25 Monoclonal Antibody (OTI4B2), TrueMAB™
{{$productOrderCtrl.translations['antibody.pdp.commerceCard.promotion.promotions']}}
{{$productOrderCtrl.translations['antibody.pdp.commerceCard.promotion.viewpromo']}}
{{$productOrderCtrl.translations['antibody.pdp.commerceCard.promotion.promocode']}}: {{promo.promoCode}} {{promo.promoTitle}} {{promo.promoDescription}}. {{$productOrderCtrl.translations['antibody.pdp.commerceCard.promotion.learnmore']}}
产品信息
TA502968
种属反应
宿主/亚型
分类
类型
克隆号
抗原
偶联物
形式
浓度
纯化类型
保存液
内含物
保存条件
运输条件
靶标信息
SNAP25 is a t-SNARE involved in the molecular regulation of neurotransmitter release. It may play a role in the synaptic function of specific neuronal systems. SNAP25 associates with proteins involved in vesicle docking and membrane fusion. It also regulates plasma membrane recycling through its interaction with CENPF. Mutations in the gene can results in myasthenic syndrome.
仅用于科研。不用于诊断过程。未经明确授权不得转售。
篇参考文献 (0)
生物信息学
蛋白别名: ALMS1; CG17676; CG17884; CG40452; Dmel CG40452; Dmel_CG40452; FLJ23079; HGNC:11132; resistance to inhibitors of cholinesterase 4 homolog; SNAP 25; SNAP-25; snp25; SUP; Super protein; Synaptosomal-associated 25 kDa protein; Synaptosomal-associated protein 25; synaptosomal-associated protein, 25kDa; synaptosome associated protein 25kDa
基因别名: bA416N4.2; CMS18; dJ1068F16.2; RIC-4; RIC4; SEC9; SNAP; SNAP-25; SNAP25; SUP
UniProt ID: (Human) P60880
Entrez Gene ID: (Human) 6616